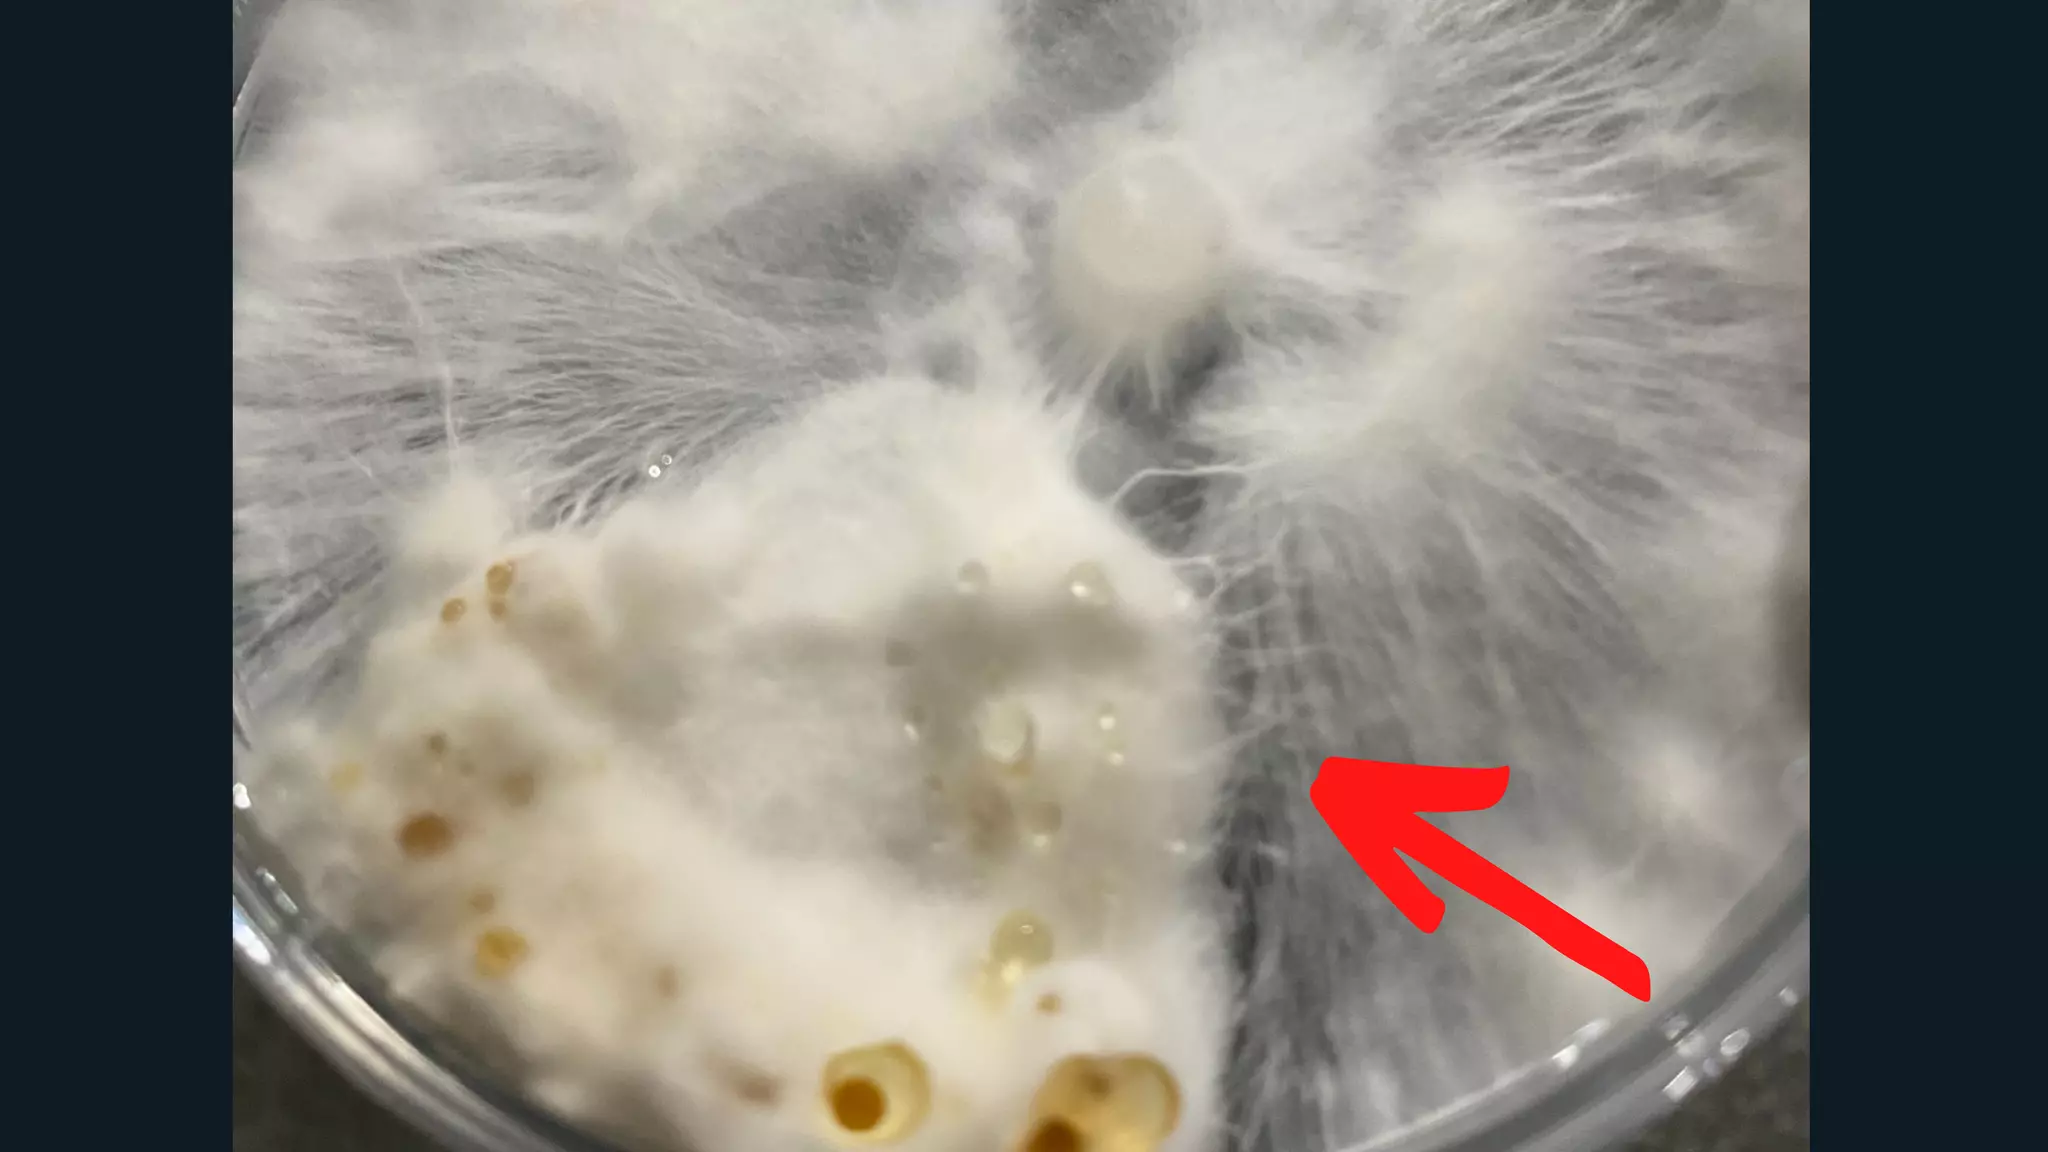
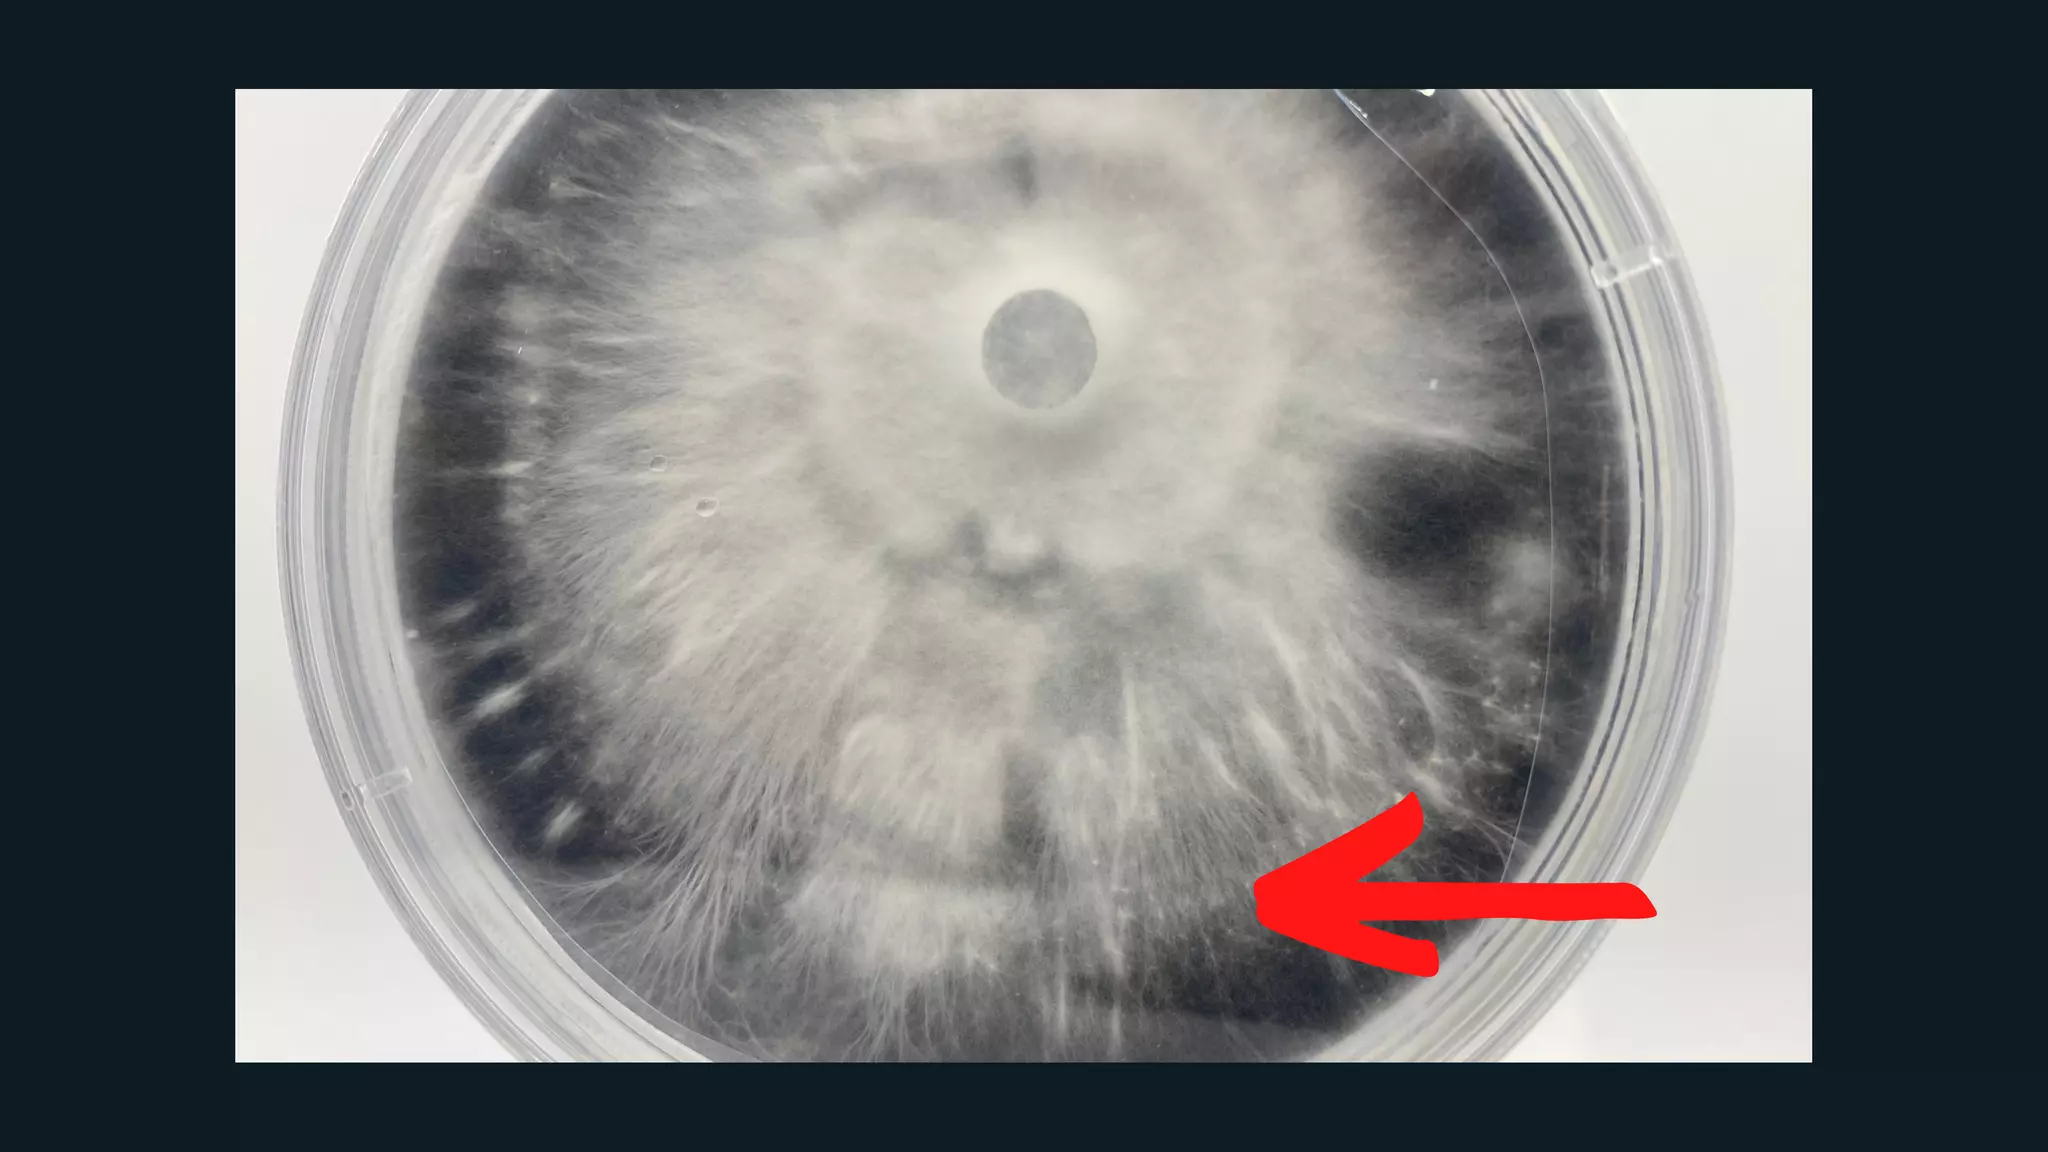

This document provides an overview of Zen principles and mycology from a presentation by Jesse Noller of The Humble Fungus. It discusses key Zen concepts like beginner's mind and impermanence. It then covers fungal biology facts, cultivation techniques like agar recipes and grain spawn preparation, and principles of fruiting like using simple fruiting chambers. The overall message is that fungi should be cultivated following natural principles through science-based and data-driven methods.